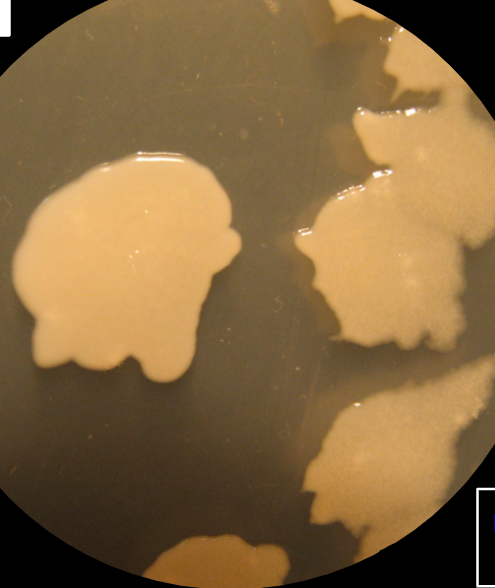
term image
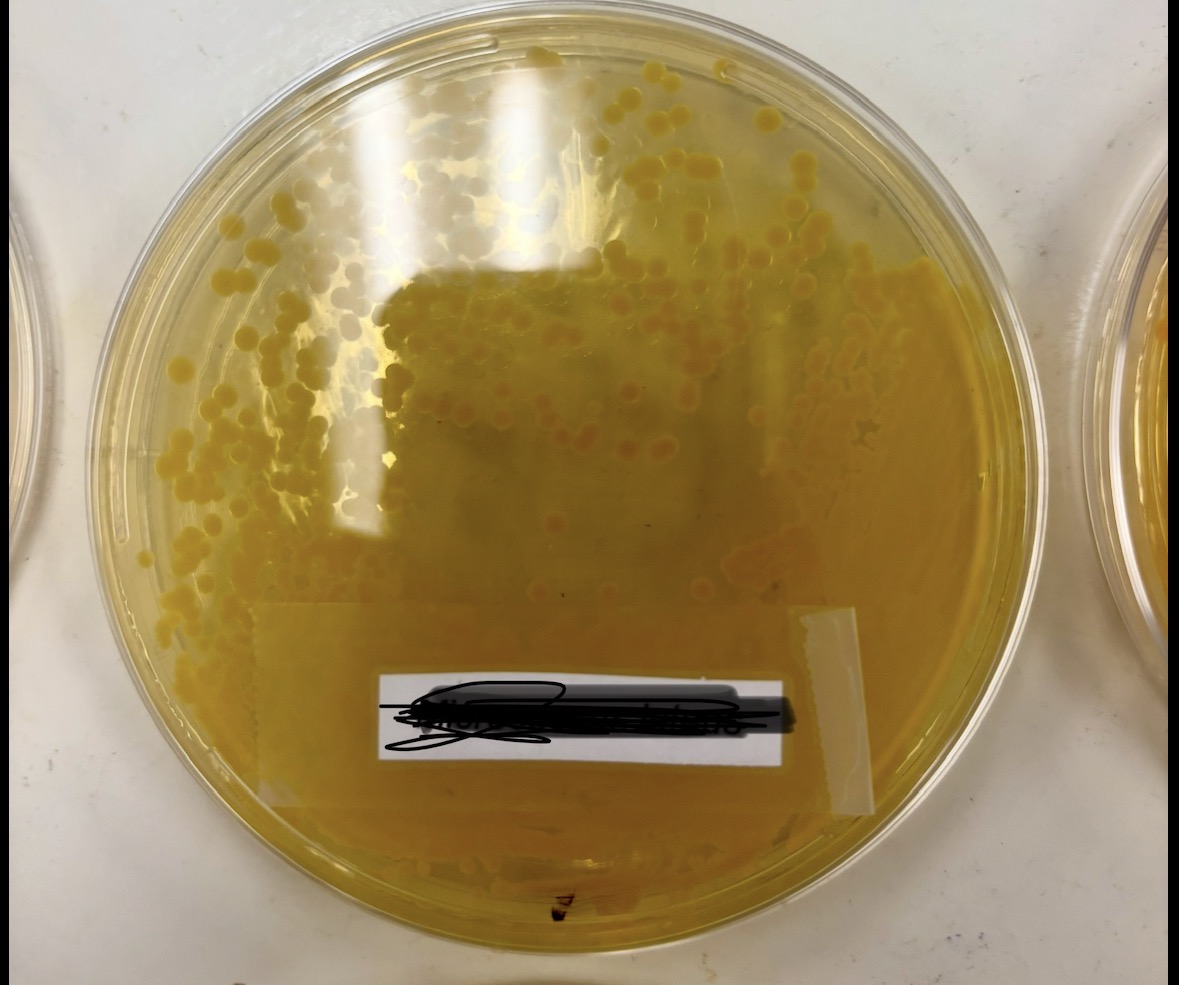
term image
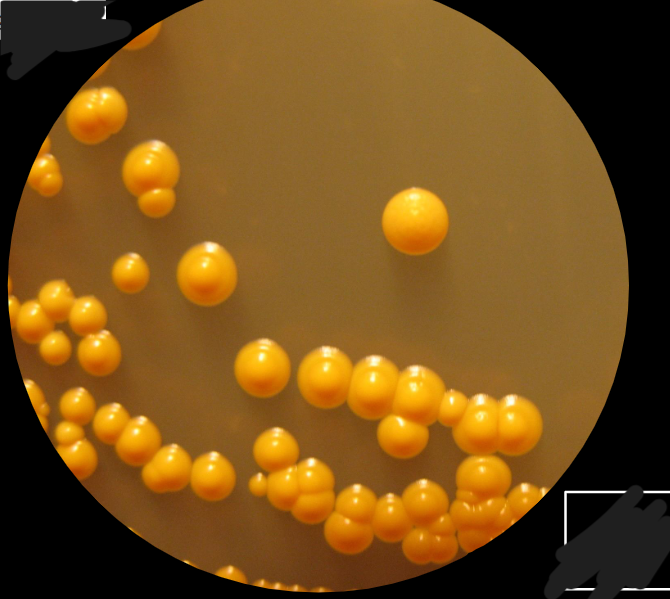
term image
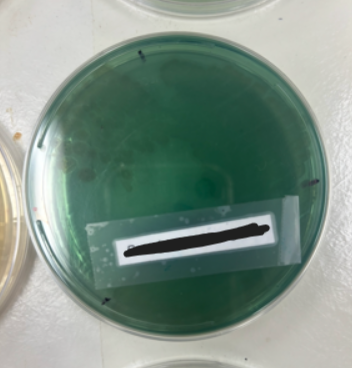
term image
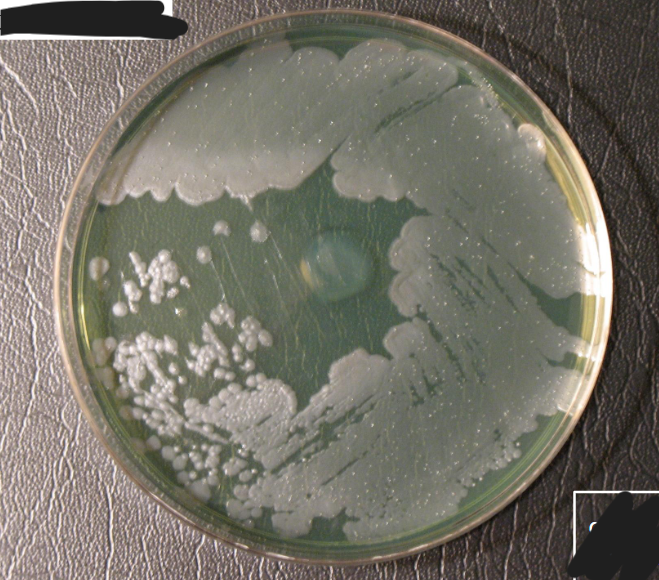
term image
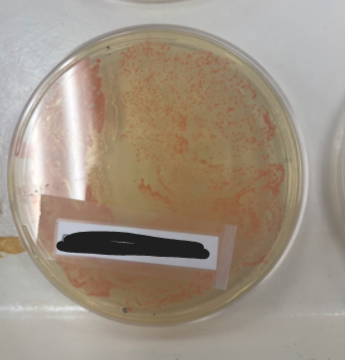
term image
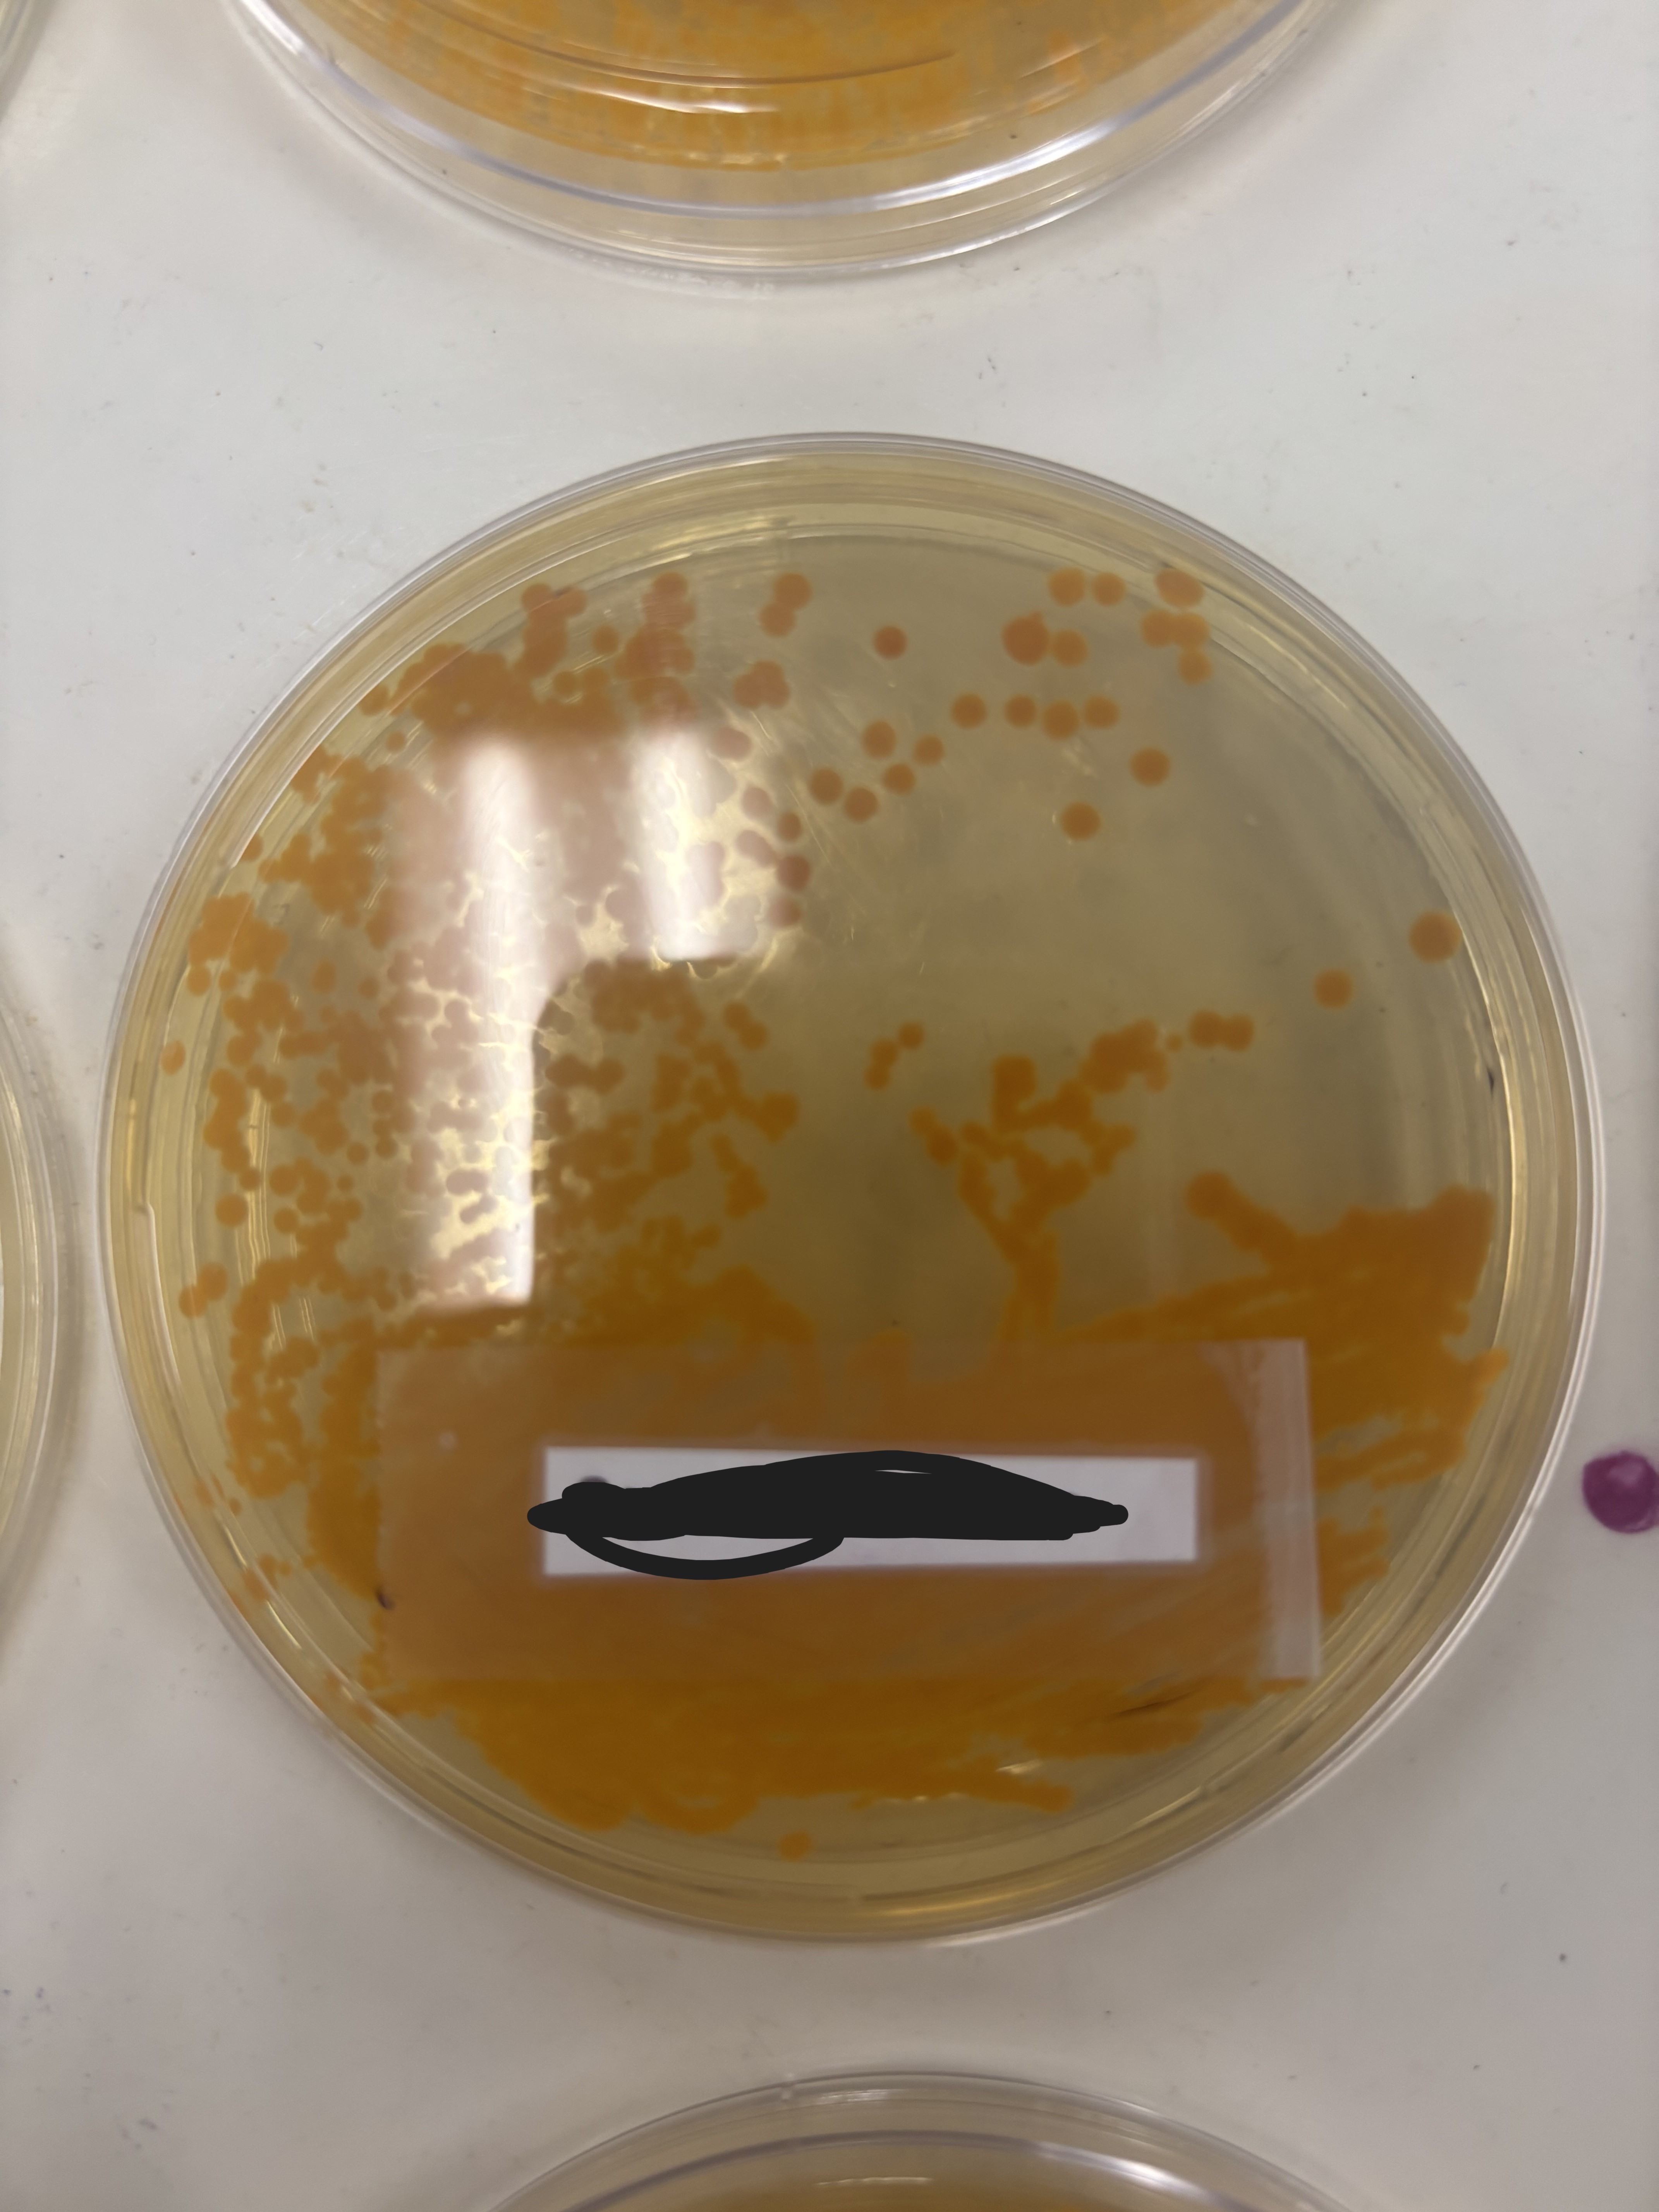
term image
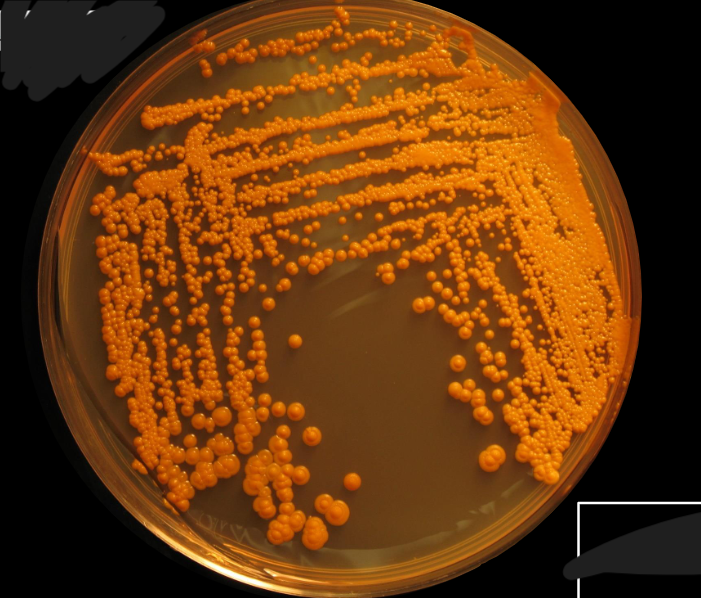
term image
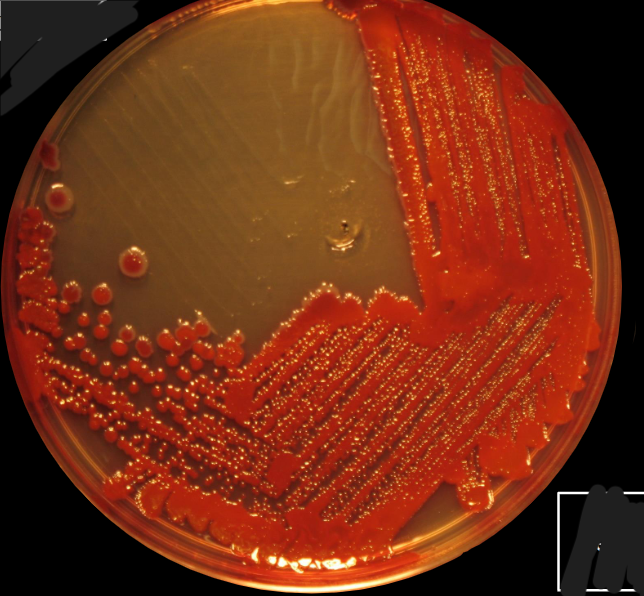
term image
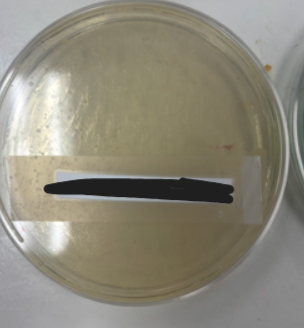
term image
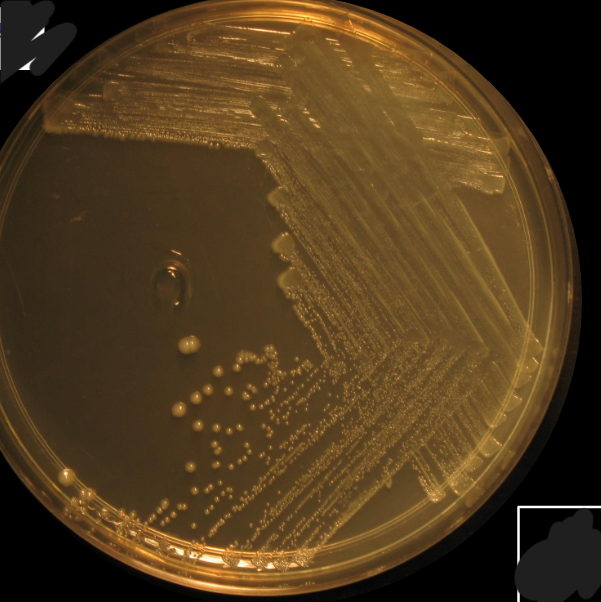
term image

Bacteria Characteristics
1/17
There's no tags or description
Looks like no tags are added yet.
Name | Mastery | Learn | Test | Matching | Spaced | Call with Kai |
|---|
No analytics yet
Send a link to your students to track their progress
18 Terms
Bacillus cereus
Characteristics of Bacillus cereus
white, circle, flat, big, opaque
Micrococcus luteus
Micrococcus luteus
Characteristics of Micrococcus luteus
yellow, convex, round, opaque, small
Pseudomonas aeruginosa
Pseudomonas aeruginosa
Characteristics of Pseudomonas aeruginosa
green, large, mucoid, irregular, flat
Rhodococcus rhodochrous
Characteristics of Rhodococcus rhodochrous
Pink, small, mucoid, convex, opaque
Sarcina aurantiaca
Sarcina aurantiaca
Characteristics of Sarcina aurantiaca
gold, umbonate?, round, convex, smooth, opaque
Serratia marcescens
Characteristics of Serratia marcescens
Red, medium, circle, smooth, convex
Staphylococcus epidermis
Staphylococcus epidermis
Characteristics od Staphylococcus epidermis
white, punctiform, small, circle, even, smooth, convex, opaque